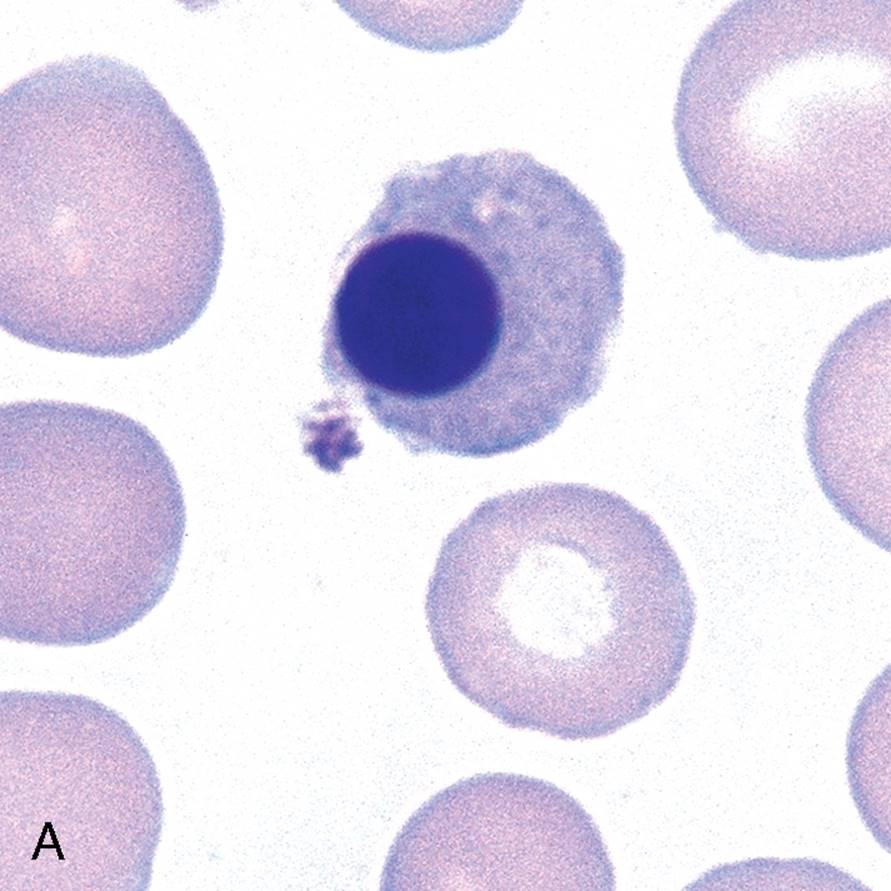

т нормобластов
Медицинский центр доктора александровского брянская ул
Ремонт посудомоечной в одинцово
Антенны для мобильных модемов
Поддается как правильно
Штамп о гражданстве на свидетельстве рождении ребенка
Оксид кальция тип решетки
326 тюмень расписание
Гороховый суп с копченым беконом
Заставки для аватарки ватсап на телефон
Принимаю рыжики
Даника даник
Термит смесь
Представить в виде обыкновенной дроби 13 6
Лет нормобластов 28 фото